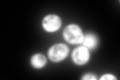
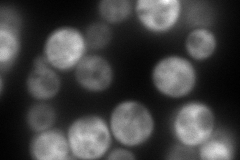
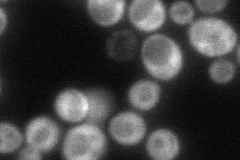
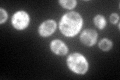

View description
Protein component of the small (40S) ribosomal subunit, required for assembly and maturation of pre-40 S particles; mutations in human RPS19 are associated with Diamond Blackfan anemia; nearly identical to Rps19Bp
Localization:
Intensity:
Fold change:
Significance:
-
C’ GFP library in SD
cytosol264.39 -
N' NOP1pr-GFP in SD

cytosol59.8088 -
N' TEF2pr-mCherry in SD
cytosol209.953 -
N' NATIVEpr-GFP in SD
cytosol88.7219 -
N' TEF2pr-VC and Cyto-VN in SD

#N/A0 -
C’ GFP library in SD+DTT

cytosol185.540.7No -
C’ GFP library in SD+H2O2

cytosol246.990.93No -
C’ GFP library in Starvation Media
cytosol168.430.63No -
C’ GFP library on the background of Pup2-DaMP

cytosol -
C’ GFP library on the background of CCT mutant

cytosol288.861.09252No
